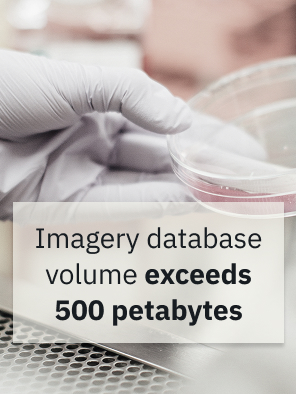
Customer

Accelerate Discovery in Healthcare and Life Sciences
Enable faster drug pioneering, genomic sequencing, microscopy, and breakthrough results in HCLS environments with the world’s fastest AI storage and memory solution
The world’s leading AI innovators and research teams build on NeuralMesh.
Faster Storage Performance Translates to Breakthrough Research and Scientific Discovery
Gain consistent, predictable performance to reduce project times from weeks to days and accelerate time to new drug discoveries and scientific insights with the highest-performance, lowest-latency
data storage system.
Expedite AI Model Training Times
Break down the memory-to-storage bottleneck with faster file access and IOPS to reduce training times by up to 20x with NeuralMesh™
Maximize ROI from Existing GPUs and CPUs
Enable greater concurrency, achieve higher throughput, and lower the cost per token for large-context inference with Augmented Memory Grid™
Streamline Multi-Protocol Operations
Eliminate redundant data copies to accelerate scientific discovery by more than 10x with NeuralMesh™ Axon™
Handle Billions of Small Files Efficiently
Scale to billions of files in a single namespace or trillions cluster-wide to accelerate access without sacrificing performance
Optimize Data Management With Zero Tuning Required
Ingest, analyze, and offload petabytes of data from raw files without manual tuning or administrative burden
Support On-Prem, Cloud, and Hybrid Pipelines
Simplify research operations with seamless cloud bursting and flexible on-premises storage access
Condense Infrastructure Footprint
Achieve exceptional performance density and multi-petabyte linear scaling in a minimal physical footprint
Ensure Access to Encrypted Data
Guarantee secure access to fully encrypted data to deliver high performance discovery even with sensitive, proprietary data
Deploy Across Highly Regulated Environments
Retain data for regulatory compliance across decades using storage layers optimized for long-term cost efficiency
NeuralMesh Offers A Proven Solution for HCLS Industry Experts
Accelerate Scientific Research With NeuralMesh
Every major scientific discovery depends on data being captured, processed, analyzed, and stored efficiently. When infrastructure becomes a bottleneck, research slows down. When infrastructure performs at scale, discovery accelerates. This is where WEKA becomes part of the story.
Common Questions, Straight Answers
The short answer is: most of them. Workflows for genomics, drug discovery, medical imaging AI, Cryo-EM reconstruction, protein structure prediction, variant calling, multi-omics analysis, and others all share a common problem. They generate enormous volumes of small files with unpredictable access patterns that legacy storage systems were never designed to handle. The result is GPU clusters sitting idle while storage tries to keep up. WEKA’s NeuralMesh architecture was built specifically for this environment, delivering parallel data access at the speed modern life sciences research actually demands.
WEKA integrates with NVIDIA GPUDirect Storage, which creates a direct path between NVMe storage and GPU memory, bypassing the CPU entirely. This removes one of the most common latency sources in AI training and inference pipelines. On top of that, WEKA is validated for NVIDIA DGX SuperPOD deployments and supports inference through the NVIDIA Triton Inference Server, meaning researchers get a fully integrated stack where storage and compute are optimized to work together rather than fighting each other. This improves speed to discovery and cuts down on overall infrastructure costs.
Slow storage doesn’t just slow research, it wastes it entirely. Every hour a GPU cluster spends waiting for data is compute budget gone with nothing to show for it. The Oklahoma Medical Research Foundation saw this problem clearly: some research jobs were taking 70 days to complete. After deploying WEKA, those same jobs finished in a week. Others dropped from 12 hours to 2. That’s not a “data storage” story. It’s a research and discovery story.
A single sequencing run produces hundreds of gigabytes of raw data and population-scale programs produce petabytes. When the challenge is both capacity and access, storage infrastructure needs to be able to support genomic pipelines that constantly open, read, and close millions of small files in rapid succession. This is the type of workload that breaks traditional NAS systems. WEKA handles this natively through its distributed metadata architecture, allowing multiple jobs to run concurrently without contention or performance degradation.
GPU utilization below 50% is common in research environments running legacy storage, not because they’re broken, but because they’re simply waiting for data. When training isn’t concurrently running, model iteration slows down and costs stack up. The Center for AI Safety ran into this problem before adding WEKA. After adding NeuralMesh, storage throughput improved 5x and research capacity expanded 6x. Their active researcher community grew from 30 people to over 200, all without adding physical footprint or power draw.
Drug discovery pipelines, including protein structure prediction, molecular docking, ligand screening, generative chemistry, and others stress storage infrastructure to the max because they run inference repeatedly across massive datasets and any I/O bottleneck compounds across thousands of iterations. WEKA’s NeuralMesh delivers the low-latency parallel access these workloads need, with the Augmented Memory Grid extending GPU memory directly to NeuralMesh storage. This helps reduce time-to-first-token (TTFT) for inference-heavy workloads. Researchers running AlphaFold and similar large biological models see this impact directly.
Regulated clinical research has requirements that most storage platforms treat as afterthoughts: FDA 21 CFR Part 11 compliance, NIST SP 800-171, GDPR, and national data sovereignty mandates. WEKA addresses these through end-to-end encryption in-flight and at rest, multi-tenancy with isolated project namespaces, and full auditability. The SIB Swiss Institute of Bioinformatics deployed NeuralMesh specifically to support the nationwide secure network, BioMedIT. This allowed all personal health data to run in an isolated, encrypted project environment and made everyone happy. Researchers get the access they need. Compliance teams get the controls they require.
Stop blaming the GPUs. Stop buying more GPUs. Start using your already owned GPUs correctly! In most cases, underutilized compute in research environments traces back to storage that can’t deliver data fast enough. NeuralMesh Axon embeds a high-performance data layer directly inside GPU servers, co-locating data with compute to cut latency at the source. The outcome is GPUs that stay busy rather than waiting.
Traditional storage architectures for research environments involve multiple tiers, separate metadata servers, redundant data copies, and a meaningful amount of rack space and power to hold it all together. WEKA replaces that complexity with a single-tier, software-defined platform that handles both large raw ingest and small-file processing without requiring data copies or manual tiering. The result? Less hardware. Lower power draw. Better performance.
The compute side is reasonably well understood at this point: CUDA for GPU acceleration, PyTorch or TensorFlow for model frameworks, AlphaFold or similar for biological modeling, Triton for inference, Kubernetes for orchestration, Slurm for job scheduling. What’s less well understood is that none of it performs to its full potential without storage that can match it. WEKA sits at the base of this stack, ensuring data moves fast enough that the rest of the investment isn’t wasted.
Modern AI architecture will have three layers: compute, storage, and data pipeline. Most organizations invest heavily in the first, adequately in the third, and underestimate the second until it becomes the bottleneck. Ultimately, that’s what happens. And that’s where WEKA comes in, providing a single high-performance namespace that spans NVMe flash and object storage, so researchers access everything at flash speed without losing a single bit of performance.